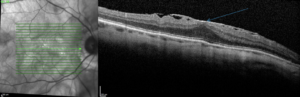
Diagnostic du Trou Maculaire
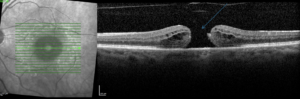
Diagnostic du Trou Maculaire

Rétine chirurgicale
Ces informations sont données à titres informatif
mais ne remplacent en aucun cas une consultation.
Certaines maladies de la rétine nécessite un traitement uniquement chirurgical : le décollement de rétine, les pathologies de l’interface vitréo-maculaire (membrane épi-rétinienne, trou maculaire, syndrome de traction vitréo-maculaire)…
Nous exerçons notre activité chirurgicale à la Clinique Saint-Roch, 560 Avenue du Colonel André Pavelet dit Villars, 34000 Montpellier.
Service d’urgences SOS RETINE 24h/24 : 04 67 60 03 40 ou 0467618800
Rétine chirurgicale
Décollement de rétine
C’est une maladie rare et grave qui peut amener à la perte de la vision. Il s’agit du détachement de la rétine neurosensorielle de son support l’epithelium pigmentaire, en partie ou en totalité.
La cause est la survenue d’un trou ou d’une déchirure dans la rétine, qui va laisser passer le liquide intra-oculaire sous la rétine.
Cause
La cause est la survenue d’un trou ou d’une déchirure dans la rétine, qui va laisser passer le liquide intra-oculaire sous la rétine.
Le décollement de rétine survient préférentiellement chez les patients d’âge moyen ou avancé, les myopes forts ou après un traumatisme oculaire sévère.
Les signes avant-coureurs peuvent être des flashs lumineux ou des taches noires qui flottent devant l’œil de façon subite. Une fois le décollement constitué, le patient se plaindra d’un obscurcissement d’une partie de son champ visuel pouvant aller jusqu’à la perte de la vision une fois la macula décollée.
Diagnostic
Le diagnostic de décollement de rétine se fait au fond d’œil. On peut s’aider de l’OCT pour juger du statut décollé ou non de la macula. On peut s’aider d’une échographie mode B en cas de trouble des milieux.


Traitement
Le seul traitement est la chirurgie. Deux techniques sont à notre disposition en fonction du cas : une technique par voie externe ou ab externo (sans rentrer dans l’œil) et une technique par voie interne ou vitrectomie (en rentrant dans l’œil par de tout petits orifices d’une taille inferieure à 1 mm). Quelque soit la technique, le but est de drainer le liquide qui est passé sous la rétine pour pouvoir la remettre à plat, puis d’obturer la déchirure par du froid (cryode) ou du laser. A tout moment en cours d’intervention le chirurgien peut être amené à modifier son plan initial.
Post opératoire
En post-operatoire, si une bulle de gaz a été injectée dans votre œil, il vous sera demandé de tenir une certaine position pour que la bulle de gaz appuie au mieux sur la déchirure le temps que la rétine cicatrice. D’autres recommandations secondaires à la présence du gaz vous seront données. La partie “Questions fréquentes” de notre site est concue pour répondre à vos interrogations à ce sujet.
Dans tous les cas il est fortement recommandé d’éviter les vibrations pendant 1 mois.
La chirurgie du décollement de rétine est une urgence relative. Cela dépend de l’ancienneté du décollement et du statut de la macula (si elle est ou non décollée). Si la macula n’est pas décollée, le décollement doit être opéré dans les 48 heures ; si elle est décollée, il doit être opéré dans les 8 jours.
Le pronostic est sévère mais les chances de réussite d’une première intervention sont bonnes. Sinon les possibilités de réintervention sont réelles. On obtient une réapplication définitive de la rétine dans 75 à 90% des cas après la première intervention, et dans 97% des cas après la seconde. Plus l’acuité visuelle initiale est mauvaise, moins la récupération visuelle est certaine. Cela dépend beaucoup de la présence ou non d’un soulèvement de la macula. Tous décollements confondus, 50% des patients atteints de décollement de rétine récupèrent 5/10ème ou plus après la chirurgie.
C’est une pathologie liée à la prolifération de cellules à la surface de la rétine qui forment une petite “peau”, préférentiellement en regard de la macula, entrainant un plissement de la rétine.
Rétine chirurgicale
Membrane épi-rétinienne
Cause
La cause exacte n’est pas connue. Cela survient plus volontiers avec l’âge.
Dans les premiers temps, la membrane épi-rétinienne entraine peu de gène visuelle. Elle évolue de façon lente et progressive pour entrainer une baisse de vision associée à des déformations des images.
Diagnostic
Le diagnostic se fait à l’OCT (Optical Coherence Tomography).
Traitement
Beaucoup de membranes restent asymptomatiques et sont découvertes par l’ophtalmologiste car le patient ne présente pas de symptômes ni baisse de vision. Dans le cas d’une membrane sans baisse visuelle, une surveillance est préconisée.
Le traitement chirurgical de la membrane est proposé en cas de baisse de vision significative avec souvent la présence de déformations visuelles. Il consiste en une vitrectomie avec pelage de la membrane épi-rétinienne avec une petite pince.
La récupération est lente et progressive après l’intervention et peut prendre jusqu’à plusieurs mois. 90% des patients perçoivent une diminution voire une totale régression des déformations. 70% des patients ont une amélioration de l’acuité visuelle après l’intervention. S’il n’y a pas d’amélioration, il y aura une stabilisation de l’acuité visuelle. Les mauvaises récupérations se voient lorsque la macula est très abimée par la membrane avant la chirurgie.
Les membranes peuvent récidiver dans 5 à 7% des cas, et nécessitent alors une nouvelle intervention.
Rétine chirurgicale
Trou maculaire
C’est une pathologie de la macula liée à des modifications du vitré survenant avec l’âge.
Formation du trou maculaire
Le trou maculaire se forme lorsque le vitré se détache de façon naturelle de la rétine, en présence d’adhérences importantes au niveau de la macula. Il entraîne une perte de substance de forme ronde au niveau de la macula, dont le diamètre va augmenter au cours des mois.
Il va petit à petit entraîner une baisse de vision de plus en plus importante avec des déformations et perte de la lecture.
Le diagnostic
Son diagnostic est fait à l’OCT (Optical Coherence Tomography).
Traitement
Le seul traitement est la chirurgie. Elle consiste en une vitrectomie avec injection de gaz. C’est-à-dire qu’aprés avoir enlevé le vitré, on va remplir l’oeil d’une bulle de gaz, afin que celle-ci appuie le plus possible sur les bords du trou pour le refermer. Ce n’est pas une urgence chirurgicale. Dans de rares cas où le trou est très petit, il arrive qu’il se referme spontanément.
Dans la majorité des cas, il vous sera demandé après l’intervention, de respecter une position particulière pendant quelques jours afin que la bulle de gaz appuie au mieux sur le trou et le referme. La position idéale est le visage tourné vers le sol, c’est-à-dire à plat ventre ou assis devant une table avec la tête reposant sur les avant-bras (= position face vers le sol ou position boudeur).
La fermeture du trou maculaire est obtenue dans 90 à 95% des cas lors de le première intervention. Cela dépend surtout de l’ancienneté et de la taille du trou. Si la fermeture du trou n’est pas obtenue après la première intervention, une réintervention est possible ; il en va de même si le trou se réouvre quelques mois ou quelques années après la première intervention.
Plus de 70% des patients ont une amélioration de l’acuité visuelle et notament une diminution des déformations et une amélioration de la vision de près. Plus le trou est ancien et de grande taille, moins bonne sera la récupération visuelle.
Rétine chirurgicale
F.A.Q
La chirurgie ambulatoire à Montpellier
Définition
La chirurgie ambulatoire est un mode de prise en charge permettant de raccourcir l’hospitalisation pour une intervention chirurgicale à une seule journée.
Définition de l’HAS (Haute Autorité de Santé) datant d’Avril 2012 :
« La chirurgie ambulatoire est réservée à la chirurgie programmée et réalisée dans les conditions techniques nécessitant impérativement la sécurité d’un bloc opératoire, sous anesthésie de mode variable, suivie d’une surveillance post opératoire permettant, sans risque majoré, la sortie du patient le jour-même de son intervention… »
- Vous entrez donc le matin pour être opéré le jour même et sortez le soir.
- L’hospitalisation varie de quelques heures à moins de douze heures.
- L’opération chirurgicale se déroule au bloc opératoire, dans les mêmes conditions que lors d’une chirurgie en hospitalisation classique.
- Tous les modes d’anesthésie sont possibles : Générale, locale, locorégionale, sédation.
Modalités de prise en charge
Le mode « Ambulatoire » vous a été proposé lors de la consultation avec le chirurgien.
Une infirmière vous appellera quelques jours avant ou la veille de l’intervention pour vous préciser l’heure à laquelle vous devrez vous présenter à l’accueil de la clinique.
N’hésitez pas à lui demander les documents administratifs dont vous avez besoin : Arrêt de travail, bon de transport , certificat de passage…
Vous serez parfaitement à jeûn (pas bu, pas mangé, pas fumé) depuis au moins 6 heures (c’est-à-dire la veille minuit) et aurez effectué la préparation selon la prescription médicale qui vous a été remise : douche à la Bétadine, soin de paupières et parfois, instillation de collyre.
Le déroulement est strictement identique à une hospitalisation classique complète.
Lorsque le chirurgien et l’anesthésiste vous ont donné le feu vert et l’heure de sortie, vous pouvez rentrer chez vous.
Vous suivrez les consignes de la prescription qui vous a été remise pour la prise d’antalgiques et les soins oculaires.
Il est nécessaire de revenir le lendemain en consultation au cabinet médical pour contrôler la tension de l’œil et l’inflammation.
Le rendez-vous vous a été donné lors de la programmation de l’intervention.
Le transport en VSL ou Taxi conventionné est pris en charge Aller/Retour pour le jour de l’intervention mais pas pour la consultation du lendemain (sauf si vous bénéficiez d’une prise en charge en ALD pour une maladie des yeux : diabète par exemple).
Les soins oculaires à effectuer en post opératoire par une infirmière libérale ne sont pris en charge que très exceptionnellement (cf document pdf ci-joint émanant de la CPAM).
Si vous n’avez pas de rendez-vous le lendemain, une infirmière du cabinet vous téléphonera le lendemain de l’opération pour s’assurer que tout s’est déroulé comme prévu.

Les positions post-opératoires : à quoi ça sert ?
Il peut vous être demandé de tenir une position spécifique, pendant quelques jours, juste après une chirurgie de la rétine. C’est souvent le cas pour les opérations du décollement de rétine ou les opérations de trou maculaire.
Cette position favorise la réapplication de la rétine en permettant au gaz ou éventuellement à l’huile de silicone d’appuyer sur la zone de rétine à cicatriser (position “boudeur = face vers le sol”, position “couché sur le côté gauche”, etc…).
Ces positions sont difficiles à tenir aussi longtemps, mais il faut savoir que le succès de la chirurgie dépend grandement du respect de la tenue de la position.
L’infirmière est à votre écoute pour vous aider à tenir la position. N’hésitez pas à lui demander conseil.
Ne faites pas les choses suivantes sans l’accord de votre médecin :
- vous coucher sur le dos
- prendre l’avion ou monter à plus de 900m d’altitude
- faire de la plongée sous-marine ou de la randonnée en montagne


Soins et précautions post-opératoires après une vitrectomie
Qu’est ce que je peux ou ne peux pas faire après une chirurgie de la rétine ?
- Poursuivez tous vos traitements, y compris les gouttes ophtalmologiques (ex : gouttes contre l’hypertension oculaire).
- Dans la journée, utilisez vos anciennes lunettes ou des lunettes de soleil comme protection, pendant 8 jours.
- Mettre la coque de protection la nuit pendant 8 à 12 jours.
- Ne pas mettre de pansement sauf si cela vous a été mentionné.
- Ne pas essuyer les yeux avec un mouchoir usagé.
- Ne pas se frotter les yeux.
- Shampoings et colorations sont autorisés en prévenant le coiffeur de bien faire attention à ne rien mettre dans l’oeil opéré.
- Vous pouvez effectuer des activités visuelles telles que la lecture, l’utilisation de l’ordinateur et regarder la télévision sans risque.
- Vous pouvez marcher.
- Vous pouvez prendre un bain ou une douche en évitant scrupuleusement de mettre de l’eau dans l’oeil opéré.
- Vous pouvez vous balader en voiture ; par contre la conduite automobile n’est pas autorisée avant de recevoir l’approbation de votre médecin.
- dans les cas où une bulle de gaz a été injectée dans votre œil lors de l’intervention, il vous sera demandé de respecter une position particulière (face vers le sol, allongé sur le coté droit ou gauche, demi-assis…).
ÉVITER pendant 1 mois :
- les sports violents (football, tennis, rugby, golf).
- tout ce qui entraine des vibrations de la tête.
- les activités sexuelles.
- porter des poids importants.
- l’utilisation d’outils de jardin ou de bricolage (tondeuse à gazon, perceuse, tracteur…).
- l’utilisation de rasoir électrique, brosse à dent électrique, ainsi que d’appareils vibrants.
- les chocs oculaires directs.
- tout ce qui peut favoriser une infection de l’oeil, comme des baignades en piscine, rivière, eau de mer…
- Évitez toute projection de corps étranger, tels que des limailles, éclats de bois, poussières ou débris lors de travaux de jardinage ou de bricolage.
- dans les cas où une bulle de gaz a été mise en place dans l’oeil (signalée par le port d’un bracelet au poignet), il ne faut pas prendre l’avion ou monter à plus de 900m d’altitude.
Comment mettre mes gouttes ?
- Commencer le traitement le soir de l’intervention ou le lendemain après retrait du pansement.

- Se laver les mains soigneusement avant de mettre les collyres.
- En cas de brûlure ou pour nettoyer l’oeil, utiliser uniquement les unidoses de serum physiologique que l’on vous a préscrites en lavage oculaire. Ne pas utiliser d’eau du robinet ou d’eau minérale.
- Instiller les collyres, après le lavage si nécessaire, en suivant cette procédure simple :
- Abaissez la paupière inférieure, sans toucher l’oeil ni la paupière supérieure avec le flacon
- Essayer de regarder vers le haut. Vous pouvez incliner la tête en arrière, vous asseoir ou vous allonger pour plus de facilité
- Placez une goutte ou une perle de pommade dans la cavité formée lorsque que la paupière inférieure est tirée vers le bas
- Respecter quelques minutes entre chaque collyre.
Il est normal de ressentir un certain inconfort après la chirurgie, que l’oeil soit sensible à la lumière, qu’il soit rouge et enflé, qu’il vous démange ou qu’il coule. Des comprimés contre la douleur vous seront prescrits. Si des points ont été mis pour suturer la conjonctive, l’inconfort persistera 2 à 3 semaines, à type de “gratouillis” ou sensation de “corps étranger”, jusqu’à résorption spontanée des points.
Il est important de poursuivre vos autres médicaments, y compris les gouttes ophtalmologiques (ex : gouttes contre l’hypertension oculaire).
J'ai des points noirs qui se baladent devant les yeux depuis 2 jours. Qu'est ce que c'est ?
Corps flottants dans l’oeil
- Est ce que je vais avoir un décollement de rétine ?
Ce sont des “corps flottants“. L’oeil est rempli d’un gel aqueux appelé le vitré. Avec les années, il se déshydrate, se liquéfie et se détache de la rétine. Ces remaniements peuvent donner cette impression de mouches volantes (dites myodésopsies) devant les yeux. C’est un processus physiologique naturel et dans la majorité des cas sans gravité. S’ils surviennent en nombre et de façon aigüe, ils peuvent révéler une déchirure rétinienne. Un examen du fond d’œil est alors nécessaire.
Si aucune lésion n’est retrouvée sur la rétine, les corps flottants ne relèvent d’aucun traitement. Le seul moyen de les enlever serait la vitrectomie c’est-à-dire l’ablation du vitré, qui comporte plus de risques que de bénéfice chez des patients qui ont en général 10/10ème d’acuité visuelle malgré leurs corps flottants. Le plus souvent ils diminuent en intensité, sédimentent en inferieur et les patients s’y habituent sans qu’ils disparaissent complètement.
- Mon ophtalmo m’a dit que j’avais “un décollement de l’humeur vitré”, c’est grave Docteur ?
Il s’agit du décollement postérieur du vitré, phénomène naturel survenant avec l’âge, de détachement du vitré de la rétine. Il survient chez tout le monde à un âge différent. Il peut entraîner des symptômes à type de corps flottants ou de flahs lumineux ou passer complétement inaperçu. Dans de rares cas, il peut être à l’origine de déchirure rétinienne périphérique qu’il est bon de dépister avant que survienne un décollement de rétine. Une telle déchirure si elle est présente se traite par laser.
- Je suis myope de -3 dioptries depuis mon enfance, est ce que j’ai plus de risque de faire un décollement de rétine ? Est ce qu’un examen du fond d’oeil annuel est nécessaire ? A partir de quel âge ?
Il ne faut pas confondre la myopie simple qui est une amétropie banale et la myopie maladie qui est une pathologie évolutive du globe oculaire susceptible d’être à l’origine de nombreuses complications.
- Le « petit » myope (de -0,25 à -6 dioptries) n’a pas plus de risque de développer des pathologies rétiniennes que la population générale ; il ne nécessite pas de dépistage particulier ou de surveillance particulière au niveau de son fond d’œil. Un fond d’oeil est recommandé seulement s’il se plaint de mouches volantes, de flahs lumineux…
- Par contre la myopie forte ou myopie maladie requiert toute l’attention de l’ophtalmologiste. C’est une myopie supérieure à -6 dioptries, ou de longueur axiale supérieure à 26 mm (la longueur axiale d’un œil normal est de 23 mm).
Du fait de l’évolutivité de l’allongement du globe oculaire au cours de la vie chez ces patients, des complications rétiniennes plus graves peuvent survenir. En effet chez le myope fort, la rétine est étirée, amincie, plus fragile et plus susceptible de se déchirer. Par ailleurs elle est plus à risque de complications maculaires. Tout symptôme (mouches volantes, flashs, déformations des images, baisse de vision…) chez le myope fort justifie un bilan rétinien complet dans la semaine.

Injection intra vitréenne (ou IVT)
- Qu’est ce qu’une injection intra-vitréenne (IVT) ?
Il s’agit d’injecter un produit spécifique (anti-VEGF ou corticoïde) directement dans le corps vitré.
- Comment se déroule une injection intra-vitréenne ?
Après avoir réalisé un bilan rétinien complet avec votre ophtalmologiste, celui-ci déterminera si un traitement par injection intra-vitréenne est recommandé en fonction de votre maladie rétinienne et de vos antécédents médicaux ophtalmologiques et généraux.
L’injection intra-vitréenne pourra être réalisée au sein du cabinet dans nos salles blanches, de façon plus ou moins urgente en fonction de la pathologie.
L’infirmière vous prendra en charge :
- elle vous fera revêtir un couvre chef, une surblouse et des surchaussures à usage unique
- elle vous fera allonger sur un divan dans la salle blanche
- elle désinfectera votre oeil et instillera plusieurs gouttes anesthésiques dans l’œil à traiter.

Le chirurgien revêt une blouse et des gants stériles.
Il appose un champ stérile autour de l’œil à traiter et réalise une deuxième désinfection. Il met en place un blépharostat pour maintenir les paupières ouvertes de façon non douloureuse, puis réalise l’injection. Tout cela ne dure que quelques secondes et vous ne ressentez rien.
- Et après l’injection intra-vitréenne ?
Les heures qui suivent l’injection peuvent être marquées par une gène due à la Bétadine utilisée pour la désinfection de l’oeil.
Vous pouvez utiliser des collyres mouillants pour soulager la gène. Votre chirurgien vous les prescrira. Il n’y a pas besoin de collyres antibiotiques.
Sinon, il peut aussi y avoir dans le liquides injecté des petites bulles microscopiques inévitables, mais que vous verrez pendant quelques heures. C’est sans danger.
Il faut éviter de se toucher ou frotter l’oeil dans les heures qui suivent l’injection, mais sinon il n’y a aucune autre précaution particulière à prendre.
Il faudra dans les jours qui suivent surveiller les signes d’une infection de l’oeil, grave mais heureusement très rare (1 sur 1000). Les signes sont l’apparition un oeil rouge et douloureux avec une baisse de vision, alors que cela allait juste après l’injection. Dans ce cas il faut avertir immédiatement le centre qui pourra vous recevoir pour un traitement adapté.
A quoi sert le laser sur la rétine ? Est-ce une opération ?
- Le laser argon permet de traiter les déchirures et trous de la périphérie rétinienne qui seraient susceptibles de causer un décollement de rétine. Le cerclage de la lésion au laser permet de créer une cicatrice solide autour de la déhiscence qui empêchera le liquide intra-oculaire de passer à travers et de soulever la rétine. Ce traitement n’empèche pas l’apparition de nouvelles déchirures. En général une à deux séances suffisent.


- Le laser sert au traitement des rétinopathies diabétiques évoluées pour stopper leur évolution vers des formes gravissimes. On traite alors au laser les zones de rétine qui ne sont plus oxygénées. Plusieurs séances sont nécessaires, de façon plus ou moins espacée en fonction de la sévérité de l’atteinte rétinienne. Le laser ne permettra pas d’améliorer la vision, il peut même entrainer une baisse de vision transitoire. Par contre il est indispensable pour sauver l’œil de complications plus graves encore.
- D’autres affections rétiniennes peuvent nécessiter un traitement par laser (choriorétinite séreuse centrale ou CRSC, macroanvrysme…)

Comment se déroule une séance de laser ? Est ce douloureux ? Est ce que je risque de perdre la vue ?
Les séances de laser se déroulent au cabinet lors d’une consultation.
Le patient est assis devant l’appareil, après dilatation pupillaire par l’instillation de collyre. Un certain nombre d’impacts laser sera appliqué avec interposition d’un verre placé sur l’œil. L’œil est insensibilisé par un collyre. La séance dure environ une dizaine de minutes.
Une sensation d’éblouissement et parfois de piqûre peut être ressentie pendant la séance de laser. Au décours, une sensation de vision floue peut y être associée. La douleur ressentie pendant la séance est très variable selon le patient, et nécessite un traitement antalgique supplémentaire dans de rares cas. Le laser multispot que nous utilisons au cabinet permet d’effectuer plusieurs impacts de laser simultanément, ce qui réduit beaucoup la gène ressentie.
Les complications graves de la photocoagulation sont rares (altérations du champ visuel, baisse de vision durable). Des complications moins graves peuvent survenir (kératites).
Dans la plupart des cas, le traitement laser des pathologies rétiniennes permet de prévenir des baisses visuelles ultérieurs graves, mais ne donnera pas de gain visuel.

Qu'est-ce que la vitrectomie ?
La vitrectomie ou ablation du vitré (gel aqueux qui remplit les ¾ de l’œil) est une technique chirurgicale qui permet d’avoir accès à la rétine.
L’opération consiste à “manger” le vitré à l’aide de tout petits instruments qui pénétreront dans l’oeil par des orifices d’une taille inferieure à 1 mm.

Cette chirurgie peut se faire sous anesthésie générale ou loco-regionale. L’hospitalisation dure en règle générale 48 heures : vous entrez la veille de l’intervention, et vous ressortez le lendemain ou le sur-lendemain. L’hospitalisation ambulatoire est aussi de plus en plus utilisée pour les vitrectomies ; dans ce cas, on rentre le matin et on ressort dans l’après-midi.
Quels sont les soins préconisés après une vitrectomie ?
- des soins oculaires avec instillations de collyres vous seront prescrits pendant un mois.
- dans les cas où une bulle de gaz a été injectée dans votre œil lors de l’intervention, il vous sera demandé de respecter une position particulière (face vers le sol, allongé sur le coté droit ou gauche, demi-assis…) afin que la bulle de gaz appuie au mieux sur la déchirure le temps que la rétine cicatrise.
- en présence de gaz dans votre œil, des recommandations particulières vous seront données :
INTERDICTION FORMELLE DE PRENDRE L’AVION OU D’ALLER EN MONTAGNE AU-DELÀ DE 900 M D’ALTITUDE DURANT LA DURÉE DE PRÉSENCE DU GAZ DANS L’OEIL
GARDER LE BRACELET AU POIGNET SIGNALANT LA PRÉSENCE DE CE GAZ DANS VOTRE OEIL, AFIN D’EN INFORMER LES ANESTHÉSISTES SI UNE INTERVENTION EN URGENCE DOIT ÊTRE PRATIQUÉE DURANT CETTE PÉRIODE
- en présence de gaz la vision est quasi nulle. Petit à petit, le gaz se résorbe et est remplacé par l’humeur aqueuse, liquide transparent spontanément sécrété par l’oeil. Lors de la résorption du gaz, une sensation de “niveau liquide” dans l’oeil est perçue par le patient, comme un niveau à bulle. C’est tout à fait normal et ce niveau va baisser progressivement avec la disparition du gaz. La bulle pourra parfois se séparer en plusieurs petites bulles avant de disparaître pour de bon. La disparition du gaz prend quelques jours à quelques semaines selon le gaz employé.
À éviter après une chirurgie de la rétine, une vitrectomie
- Se frotter l’œil/toucher à l’œil opéré
- Mouiller l’œil opéré durant la toilette, shampooing, ou piscine durant les 8 premiers jours post-opératoires
- Maquiller l’œil opéré durant 15 jours
- Le port des lentilles est proscrit pendant un mois
- Utiliser tout appareil provoquant des vibrations (rasoir électrique, tondeuse à gazon, tracteur…)
- Faire une activité physique, sportive demandant un effort important ou avec un risque de contusions oculaires (port de charges lourdes, activités sexuelles, jardinage…)
- S’exposer au sable ou à la poussière (plage, travaux agricoles, rénovation…)
- Conduite d’un véhicule pendant 15 jours
- En cas de présence de gaz : ne pas prendre l’avion ou aller à plus de 900m en altitude pendant 1mois
Quelles sont les complications possibles après une vitrectomie ?
Quelque soit l’indication de chirurgie, des complications peuvent survenir. Elles sont heureusement très rares.
- l’infection : malgré des précautions soigneuses et permanentes au bloc opératoire, ce risque existe comme dans toute chirurgie. Il est de 1 pour 1000. Même si l’infection intra-oculaire post-opératoire reste une complication grave, le traitement antibiotique est efficace dans la majorité des cas. Des formes rares peuvent malgré tout conduire à la perte fonctionnelle de l’oeil.
- le décollement de rétine peut survenir après une vitrectomie bien conduit : le risque est de 1 à 5% environ, auquel cas une nouvelle intervention est nécessaire.
- d’autres complications peuvent survenir après une chirurgie rétinienne : une hypertonie intra-oculaire, une réaction inflammatoire exagérée, le plus souvent jugulées par des traitements médicamenteux locaux et/ou généraux. Plus rarement, une ré-hospitalisation de quelques jours sera nécessaire.
La cataracte est un effet secondaire prévisible assez fréquent après une vitrectomie, d’autant plus si du gaz a été utilisé. Elle survient dans les mois qui suivent l’intervention et nécessite alors une chirurgie de la cataracte à l’aide des techniques standard.
